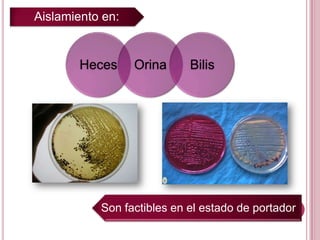
Náusea

Incrustar presentación
Descargado 1149 veces
























Este documento describe la fiebre tifoidea, causada por la bacteria Salmonella typhi. Se transmite principalmente a través de alimentos o agua contaminados, o de persona a persona a través de contacto anal-oral. Los síntomas incluyen fiebre, dolor abdominal y diarrea. Las complicaciones pueden incluir perforaciones intestinales, hemorragias o meningitis. El diagnóstico se realiza mediante un coprocultivo.